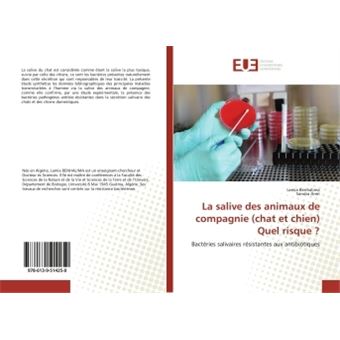
Verrou De Poubelle, Verrou De Poubelle Pour Animal S'Adapte à Une Poubelle De 30-50 Gallons, Verrou/sangle De Couvercle De Poubelle Réglable Avec Griffe En Métal

AS Roma Tracksuits, AS Roma Track Suit
Description du produit
Avis
Négatif, positif, neutre ; quel qu'il soit, nous publions chaque avis. Nous vérifions d'abord s'il répond aux conditions et s'il est authentique. Nous vérifions également qu'il ait été écrit par quelqu'un qui a acheté l'article via johnhydeengineering.co.uk. Le cas échéant, nous le mentionnons. Les contrôles sont automatiques, même si des collaborateurs y jettent parfois manuellement un oeil. JOHNHYDEENGINEERING.CO.UK n'offre pas de paiement pour ces avis. Si un évaluateur a reçu une compensation d'un tiers, cette information est indiquée dans l'évaluation elle-même.
Négatif, positif, neutre ; quel qu'il soit, nous publions chaque avis. Nous vérifions d'abord s'il répond aux conditions et s'il est authentique. Nous vérifions également qu'il ait été écrit par quelqu'un qui a acheté l'article via johnhydeengineering.co.uk. Le cas échéant, nous le mentionnons. Les contrôles sont automatiques, même si des collaborateurs y jettent parfois manuellement un oeil. JOHNHYDEENGINEERING.CO.UK n'offre pas de paiement pour ces avis. Si un évaluateur a reçu une compensation d'un tiers, cette information est indiquée dans l'évaluation elle-même.
Livraison
Nous mettons tout en oeuvre pour livrer cet article à temps. Des circonstances exceptionnelles peuvent toutefois retarder votre colis.
Options de livraison
Différentes options s'offrent à vous pour la livraison ou le retrait de votre commande. Les options exactes disponibles pour cette commande sont visibles lors du paiement.
- Livraison gratuite dès 25 €
- 30 jours de réflexion et retour gratuit
- Service client 24h/24
- Livraison en soirée même en semaine
- Commandé en semaine avant 12h, livré chez vous aujourd'hui (entre 17h et 22h)
- Livraison en soirée même en semaine
- Livraison aussi le dimanche (pour toute commande passée avant samedi 23h)
Articles sponsorisés
Signaler cet article
Vous souhaitez signaler un contenu illégal, comme un article dangereux, illégal ou un contenu trompeur.
- Je souhaite faire un signalement en tant que client.
- Je veux faire un signalement en tant qu'autorité ou personne de confiance.
- Je veux faire un signalement en tant que propriétaire de partenaire
- Je veux faire un signalement en tant que propriétaire de marque
Vous n'êtes pas un client, une autorité, personne de confiance, propriétaire de marque ou un partenaire? Dans ce cas, utilisez le formulaire client (via le bouton ci-dessous) pour effectuer un signalement.